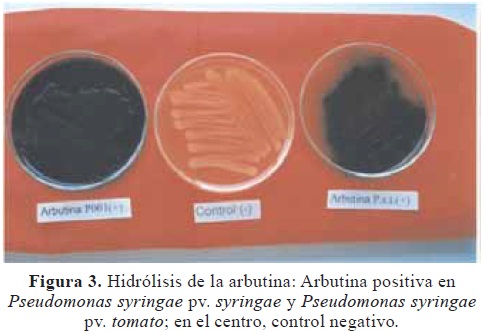

Services on Demand
Journal
Article
Indicators
-
 Cited by SciELO
Cited by SciELO -
 Access statistics
Access statistics
Related links
-
 Cited by Google
Cited by Google -
 Similars in
SciELO
Similars in
SciELO -
 Similars in Google
Similars in Google
Share
Revista de la Academia Colombiana de Ciencias Exactas, Físicas y Naturales
Print version ISSN 0370-3908
Rev. acad. colomb. cienc. exact. fis. nat. vol.35 no.134 Bogotá Jan./Mar. 2011
FITOPATOLOGÍA
1 Maestría en Fitopatología, Universidad de Caldas. Correo electrónico: orellanasumapaz@hotmail.com
2 Coordinador Maestría en Fitopatología, Facultad de Ciencias Agropecuarias, Universidad de Caldas, Correo electrónico: jairo.castano_z@ucaldas.edu.co
Resumen
En los municipios de Villamaría y Manizales (Caldas) se presentó una enfermedad en los árboles de duraznero [Prunus persica (L.) Batsch] con incidencia del 100%. Los síntomas eran flacidez en las hojas, defoliación y secamiento de ramas. éstas presentaban lesiones con aspecto de cáncer con exudados de goma. Una bacteria Gram negativa, fluorescente, fue aislada de tejidos enfermos en medios King's B y agar nutritivo. Las pruebas LOPAT revelaron: levano positivo; oxidasa, pudrición blanda de papa y arginina dihidrolasa negativa; y reacción de hipersensibilidad positiva en tabaco. La patogenicidad fue confirmada inoculando plántulas de duraznero de un año, las cuales presentaron síntomas similares a los observados en campo. Pruebas bioquímicas y fisiológicas indicaron que la bacteria que causa la Muerte descendente del duraznero en Caldas pertenece a Pseudomonas syringae pv. syringae.
Palabras clave: bacteria, Muerte descendente, duraznero, patogenicidad, Pseudomonas syringae.
Abstract
A disease in peach trees [Prunus persica (L.) Batsch] was dectected in the municipalities of Villamaría and Manizales (Caldas) with an incidence of 100%. The symptoms of the disease were flaccidity of the leaves, defoliation and drying of branches. Infected plants showed lesions resembling cankers with gum exudation. A Gram negative and fluorescent bacterium was isolated from diseased tissues in King's B and nutrient agar media. The LOPAT tests showed: levano positive; oxidase, potato soft rot, arginine dihydrolase negative; and positive tobacco hypersensitivity reaction in tobacco plants. The pathogenicity of the bacterium was demonstrated by inoculating one year old peach trees, which showed similar symptoms to those observed in the field. Both biochemical and physiological tests indicated that the bacterium causing the dieback in peach at the department of Caldas belongs to Pseudomonas syringae pv. syringae
Key words: bacterium, Dieback, peach, pathogenicity, Pseudomonas syringae
Introducción
Los frutales caducifolios tienen una creciente demanda comercial a nivel de fruta fresca; ésta demanda requiere técnicas que permitan incrementar las cosechas como base para competir con una producción abundante y de buena calidad (Pachón & Bridg, 1993). La producción nacional de duraznero ha estado representada en huertos caseros y algunos cultivos ubicados en los departamentos de Boyacá, Cundinamarca, Santander, Antioquia, Caldas y Nariño. Debido a la introducción de materiales con bajo requerimiento de frío, las áreas se han incrementado en estas regiones del país pasando de 450 a 850 ha en el año 2005 (Molina & Parra, 2007). Para el 2009, los departamentos que se destacaban por su producción eran: Boyacá con 915 ha y el Norte de Santander con 321 ha con rendimientos de 13 y 11,9 ton ha-¹, respectivamente (Agronet, 2009). Se observa un incremento muy significativo en el área cultivada ya que en el año 1986, fue de 260 ha en todo el país (Campos, 1993). En los municipios de Villamaría y Manizales (Caldas), específicamente en las fincas Valles y Guamal en Villamaría y Los Manzanos en Manizales, ubicadas entre 2.100 y 2.200 msnm, respectivamente, se presentó una enfermedad en los cultivos de duraznero, afectando a las variedades Newball, Sapote, Florida y Amarillo. Los síntomas externos observados eran flacidez de las hojas, con posterior defoliación y secamiento de ramas. Las ramas presentaban lesiones con aspecto de cáncer con exudados gomosos y finalmente los árboles morían. Al hacer cortes transversales de ramas se observaba una coloración parda oscura, que iba en forma descendente a través de ramas y tallos.
Las observaciones de campo y la percepción de los cultivadores de la región indicaban un incremento en la severidad de la enfermedad en épocas lluviosas y húmedas, mientras que en épocas secas, la enfermedad tendía a estabilizarse. La razón de la severidad de la enfermedad era desconocida, pero parecía factible que una combinación de factores predisponentes, particularmente climáticos de suelo, y el uso de materiales susceptibles favorecían su expresión. En los cultivos de duraznero de Boyacá, Cundinamarca y Nariño no se reportaban daños de ésta naturaleza.
En duraznero se presentan diferentes enfermedades con características devastadoras como: Cáncer bacteriano provocado por Pseudomonas syringae pv. syringae Van Hall y P. syringae pv. persicae (Prunier et al.) Young et al., el cual conduce a la muerte de plantas jóvenes en un lapso de un año y de adultas en dos ó tres años (Noval, 1991). Hattingh et al. (1989) reportan la muerte de más de un millón de árboles de duraznero en Francia por causa de ésta enfermedad. Entre los hongos que causan marchitamentos y daños en tallo y ramas se encuentran los géneros Leucostoma, Verticillium, Ceratocystis, Phomopsis y Botryosphaeria (Gubler, 1995).
El agente causante de la enfermedad aún no se ha identificado y se desconocen los factores predisponentes que favorecen su desarrollo impidiendo el diseño de estrategias efectivas de manejo. Esta investigación propuso abordar los procedimientos adecuados para el diagnóstico correcto del agente o los agentes causantes de la Muerte descendente del duraznero como paso fundamental para el diseño de prácticas de manejo que permitan proteger los cultivos con la perspectiva de mejorar la rentabilidad de las inversiones sin deteriorar el ecosistema por el uso de prácticas inadecuadas de manejo.
Materiales y métodos
La investigación se inició con el muestreo en la finca Guamal localizada en el municipio de Villamaría (Caldas) ubicada a 2.100 msnm; con temperatura promedio anual de 15,5°C, precipitación promedio acumulada anual de 2.100 mm y una humedad relativa del 80%; y en el municipio de Manizales en la finca Los Manzanos, localizada en la vereda Maltería, ubicada a 2.200 msnm; con temperatura promedio de 17°C y precipitación promedio acumulada anual de 2.200 mm y una humedad relativa del 88%. Las pruebas preliminares se llevaron a cabo en el laboratorio de Caducifolios, del departamento de Fitotecnia, de la Universidad de Caldas, Manizales, cuyas características son: temperatura promedio 18 °C, humedad relativa 73,3 % y altitud 2.200 msnm.
Toma de muestras y procesamiento. Se recolectaron muestras de ramas, tallo, y raíces de árboles de tres años y medio de edad, de las variedades Newball, Florida, Sapote y Amarillo, sembradas a una distancia de 4x5 m. Básicamente el manejo sanitario de las plantaciones consistió en realizar podas y aplicación de benomil sobre las heridas en dosis de 1 cm3 L-1 de agua . Las ramas fueron tomadas principalmente donde se observaba el avance de la enfermedad. Las muestras se colocaron bajo un estereoscopio, para observar crecimientos miceliales ó estructuras de algún hongo. Una parte de cada muestra se colocó en cámara húmeda (Del Río & Sauceda, 1997). Luego de ésta observación se procedió a realizar siembras por aislamiento directo, así: se lavaron las partes colectadas enfermas con agua corriente y luego se sumergieron en una solución de hipoclorito de sodio al 2% durante 2 ó 3 min y se enjuagaron nuevamente con agua destilada estéril. Luego en una cámara de aislamiento y con un bisturí estéril, se hicieron cortes de 1 a 2 mm2 en la zona de avance de la enfermedad y se depositaron durante 2 min en una caja Petri que contenía una solución de hipoclorito de sodio al 2%, posteriormente se pasaron con una pinza estéril a otra caja Petri conteniendo agua destilada estéril. Finalmente, fueron depositados en papel secante estéril para retirar el exceso de humedad. Estas muestras se sembraron en papa, dextrosa, agar (PDA) acidificado, el cual se preparó disolviendo 39 g de PDA en 1 L de agua y esterilizado en autoclave a 121 °C y 15 lb de presión, durante 20 min. Se vertió de 20 a 25 mL por caja Petri, y se adicionó dos gotas de ácido láctico al 25% con el propósito de bajar el pH entre 4 y 5 para inhibir el desarrollo de bacterias (Del Río & Sauceda, 1997); igualmente se sembraron tejidos en agar nutritivo (AN) marca Oxoid (agar 15 g; peptona 5 g; extracto de carne 4 g), para el aislamiento de bacterias, el cual se preparó disolviendo 24 g de AN en 1 L de agua, se dejó hervir por 1 min, se esterilizó en autoclave y se vertió en cajas Petri. Las siembras se dejaron a una temperatura de 26°C, en una estufa de temperatura controlada marca DIES, por espacio de 72 h. Al desarrollarse bacterias alrededor del tejido, se hizo resiembras para separar las colonias y se procedió a purificar las bacterias por el método de estría o agotamiento, el cual consiste en hacer trazos sobre el medio de cultivo para ir diseminando la bacteria sobre la superficie del medio. Para esto se tomaron cuatro cajas Petri con AN, las cuales se sembraron así: se tomó el asa previamente flameada y fría con el crecimiento bacteriano alrededor del tejido y se trazaron estrías en forma de zig zag en las placas una y dos sin flamear la aguja, se repitió la operación con las placas tres y cuatro pero trazando estrías, se dejaron incubar a 26°C durante 24 a 36 h. Las cajas fueron observadas diariamente registrando el tiempo de aparición y las características de la colonia como color, forma y brillo. A partir de éstas colonias puras aisladas, se realizó la resiembra en medio King's B (Peptona 20 g, K2HPO4 3H20 2,5 g, MgSO4 7H2O 6 g, glicerol 15 mL, agar 15 g), para la detección de pigmentos fluorescentes y se dejaron en incubación durante 72 h al cabo de los cuales fueron examinadas bajo una lámpara de luz ultravioleta. Además se sembró en medio D-4, el cual contiene glicerol, sucrosa, caseína enzimática hidrolizada, NH4Cl, NaHPO4, dodecil sulfato de sodio y agar, selectivo para bacterias del género Pseudomonas fluorescentes, oxidasa negativa (Shaad, 1980). La bacteria fue conservada en tubos de ensayo con agar infusión cerebro—corazón, BHI, marca Oxoid (infusión cerebro, 200 g; infusión corazón, 250 g; peptona, 10 g; NaCl, 5 g; fosfato disódico, 2,5 g; dextrosa, 2 g y agar 15 g).
Pruebas morfológicas. A partir de los cultivos puros se hicieron las pruebas morfológicas de tinción de Gram, solubilidad en KOH, movilidad en gota suspendida, catalasa y tinción de flagelos (Del Río & Sauceda, 1997; Shaad,1988; Noval,1991).
Pruebas de patogenicidad. Para éstas pruebas se preparó una suspensión bacteriana, tomando una asada de siembra estéril de bacterias procedentes de un cultivo joven (24-26 h), la cual se depositó sobre agua estéril, se homogenizó y se ajustó su densidad basada en la escala de opacidad de McFarland que se prepara mezclando las dos soluciones siguientes: A) Cloruro de bario (Cl2 Ba) al 6% y B) ácido sulfúrico (H2SO4) al 1% (Noval, 1991). Las lecturas se efectuaron comparando al trasluz la opacidad del tubo problema con la opacidad de los de la escala; para éstas pruebas se utilizaron tubos con concentraciones mayores al número uno, con una densidad de 3x107 bacterias / mL de agua.
Inoculación en frutos de durazno. En dos campanas provistas de agua en el fondo, se colocaron seis duraznos maduros previamente lavados y desinfestados con hipoclorito de sodio al 2 %. Cuatro de los seis frutos fueron pinchados con una aguja estéril y luego con una jeringuilla se puso una gota de suspensión bacteriana a una concentración de 3x107 bacterias/mL. Los orificios fueron cubiertos con algodón empapado en agua destilada estéril y se aseguraron con parafilm. Los frutos se dejaron en incubación de 48 a 72 h. De la misma forma se inocularon dos frutos de cada campana con agua destilada estéril como control.
Inoculación en hojas de duraznero. En 10 cajas Petri estériles, sobre cuatro capas de papel filtro humedecido estéril, se colocaron cuatro hojas de duraznero previamente lavadas y desinfestadas con hipoclorito de sodio al 0,5%, las cuales fueron inoculadas utilizando dos cuchillas de afeitar tipo Minora, puestas en un mango de madera tipo valso y aseguradas con chinches. Se realizaron heridas en la nervadura principal y en los bordes, luego de ser sumergida en la misma suspensión bacteriana utilizada en la prueba anterior. Los controles se realizaron haciendo el mismo corte en las hojas, pero con agua destilada estéril.
Postulados de Koch. Para aplicar estos postulados, se utilizaron plantas de duraznero (Prunus persica L.) de un año de edad, variedad Florida Bell, sobre patrón Durazno Blanco Común, provenientes del vivero Frutales de Nariño (Ipiales, Nariño) donde no se ha reportado ésta enfermedad. Las plantas fueron sembradas en bolsas plásticas de 5 kg con una mezcla de arena:suelo (1:2), abonado con gallinaza y se ubicaron bajo techo en el jardín botánico de la Universidad de Caldas, ubicado a 2.150 msnm con unas condiciones climáticas de humedad relativa de 82,6 % y una temperatura promedio de 18°C. Las plantas fueron fertilizadas con 15-15-15 (NPK) a una dosis de 1,44 g por planta cada tres semanas. La bacteria fue inoculada a una concentración de 1,5x108 bacterias/mL de agua (Tello et al., 1991) correspondiente al tubo dos de la escala de opacidad de MacFarland, utilizando cuatro plantas en cada método de inoculación y dos como testigo, las cuales fueron tratadas de igual forma pero con agua destilada estéril. Luego de ser inoculadas, las plantas fueron asperjadas con agua, cubiertas completamente con bolsas de polietileno sostenidas por palos de valso y amarradas con cauchos en la parte inferior alrededor de la bolsa para así proveer una cámara húmeda, las cuales fueron retiradas a los tres días después de la inoculación. Se hizo observación de los síntomas desarrollados y se procedió a hacer un nuevo aislamiento del patógeno.
Tratamiento 1. La suspensión bacteriana fue inyectada con una jeringa de tuberculina en los internudos inmediatamente debajo del pecíolo de la quinta hoja expandida de cada rama; las hojas anterior y posterior se marcaron con una X usando un marcador indeleble.
Tratamiento 2. Se inyectó la suspensión bacteriana en el punto de inserción de las ramas con el tallo principal.
Tratamiento 3. Se realizaron cortes en los ápices de las ramas y se inyectaron con la suspensión bacteriana.
Tratamiento 4. Se hizo inoculación en hojas asperjándolas previamente con carborundum, para provocar heridas y así permitir la entrada de la bacteria. Se hizo presión de la hoja entre el dedo pulgar sobre la haz y el envés sostenido con los otros dedos, luego se asperjó la suspensión bacteriana sobre las hojas a tratar con un aspersor manual casero marca Plasti hogar.
Pruebas fisiológicas y bioquímicas. Se realizaron las pruebas LOPAT (Levano, Oxidasa, Papa, Arginina y Tabaco), claves para discriminar Pseudomonas fluorescentes, propuestas por Lelliott et al. (1966).Como referencia se utilizó una cepa de Pseudomonas syringae pv. tomato a la que se denominó (Pst). Igualmente la bacteria en estudio se codificó como (P001). Otras pruebas realizadas fueron: reducción de nitratos, hidrólisis de la gelatina, utilización de la glucosa O/F, desarrollo a 41°C, hidrólisis de la esculina e hidrólisis de la arbutina (Shaad, 1988).
Producción de la toxina siringomicina. De un aislamiento bacteriano desarrollado en caldo nutritivo por 24 h, fue puesta una gota de 10 mL en el centro de una caja Petri con papa-dextrosa-agar (PDA) y dejado 6 días a temperatura ambiente. Luego se hizo una suspensión con el hongo Geotrichum candidum, tomando el hongo cultivado por estriado en dos cajas de PDA. A cada una se le agregó 5 mL de agua destilada estéril, raspando suavemente el inóculo con una asa para no arrastrar PDA, y se vació en un beaker estéril. La operación se repitió con la segunda caja y se agregó 40 mL más de agua destilada estéril. Luego se asperjaron las cajas con la ayuda de un aspersor de uso doméstico marca Plasti hogar. La zona de inhibición fue medida de las márgenes de la colonia bacteriana 24 h mas tarde (Gross & DeVay, 1977). Se hicieron cuatro replicas y dos testigos los cuales solamente fueron asperjados con el hongo sin la bacteria presente.
Utilización de fuentes de carbono. Los cultivos de las bacterias P001 y Pst fueron sembrados en tubos que contenían el medio basal Hugh y Leifson (H y L); (peptona, 2 g; D(+) glucosa, 10 g; azul de bromotimol, 0,03 g; agar, 2,5 g; NaCl, 5 g y fosfato dipotásico, 0,3 g en 1L de agua) previamente esterilizados a 121°C por 20 min y enfriado. Se preparó la solución de cada azúcar a una concentración final de 0,1% y fue adicionada a los tubos previamente micro filtrados con filtros milipore GSWP 02500 con un tamaño de poro 0,22 µ en un portafiltro Swinnex 25 mm. La microfiltración es utilizada para preservar intactas las proteínas que sufren desnaturalización ó la descomposición de algunos azúcares por las temperaturas de esterilización (Shaad, 1988). Se adicionó a cada tubo 5 mL del medio basal. Las colonias bacterianas de 24 h de desarrollo en AN fueron inoculadas con un asa recta, de cada azúcar probada se dejó un tubo control el cual fue inoculado con agua destilada estéril. Un cambio de color verde a amarillo que contrasta con el verde del control y el crecimiento de la bacteria alrededor del punto de inoculación fue registrado como positivo para el desarrollo en presencia de la fuente de carbono evaluado, las cuales fueron: arabinosa, ribosa, xilosa, mannosa, cellobiosa, sucrosa, rhamnosa, maltosa, manitol, adonitol, inositol, sorbitol, betaine, trigonelline, erythitol, ácido L láctico, ácido L tartárico y tartrato. Los tubos fueron incubados durante 48 a 72 h a 26°C.
Resultados
Aislamiento de la bacteria. En cámara húmeda y en las siembras en PDA, no se encontraron crecimientos fungosos. Es de anotar que en las raíces no se encontró la bacteria tal como lo describe Byther (1981). En los tallos y ramas donde se presentaban cánceres y en el avance de la muerte descendente de ramas y tallos se aisló por siembra directa en forma consistente una bacteria en medio agar nutritivo (AN) después de 72 h de crecimiento. Las características de la colonia bacteriana aislada de ramas y tallos en AN fueron: color: blanco—crema—brillante, forma circular, margen entera, elevación convexa. La bacteria creció en el medio D-4 selectivo para Pseudomonas fluorescentes, oxidasa negativa y en medio King's B, presentó un color verde manzana brillante bajo luz ultravioleta, lo que indica la presencia de fluorescencia.
Pruebas morfológicas. Estas pruebas revelaron que tanto la bacteria P001 como la Pst eran Gram (-), móviles con uno ó dos flagelos polares y catalasa positiva.
Pruebas de patogenicidad
Inoculación en frutos de durazno. Los duraznos inoculados con el aislamiento P001, mostraron una coloración café un poco hundida a los tres días después de inoculación; los duraznos control no presentaron esta coloración.
Inoculación de hojas de duraznero. En el sitio de corte hubo necrosamiento y se formó un halo clorótico; en las hojas control se observó el corte sano.
Postulados de Koch. A los siete días después de la inoculación se evaluaron los tratamientos con los siguientes resultados:
Tratamiento 1. Las ramas inoculadas presentaron secamiento, amarillamiento y flacidez de las hojas cercanas al punto de inoculación. En la parte que se hizo la inyección empezó el necrosamiento hacia la parte terminal de la rama con caída posterior de hojas. Todas las ramas inoculadas presentaron síntomas. Las hojas de las plantas control permanecieron verdes y en posición horizontal (Figura 1A).

Tratamiento 2. Empezó el necrosamiento de la base de las ramas hacia arriba principalmente en las ramas tiernas. Se presentaron exudados gomosos en los puntos de inoculación y también hubo caída de hojas (Figura 1B).
Tratamiento 3. Hubo marchitamiento en los terminales de las ramas inoculadas y avanzando hacia la parte inferior; en algunas hojas, el necrosamiento avanzó por las nervaduras principal y secundarias (Figura 2A).

Tratamiento 4. Solamente se presentó una quemazón como daño mecánico y no se notó marchitamiento ni amarillamiento de las hojas (Figura 2B). No se presentó marchitamiento en ramas, como en los tratamientos 1, 2 y 3.
Características fisiológicas y bioquímicas. Las pruebas LOPAT revelaron colonias tipo levano positivo; oxidasa, podredumbre en papa y arginina dihidrolasa negativos; e hipersensibilidad en tabaco positivo. Los aislamiento bacterianos P001 y Pst fueron negativos en las pruebas reducción de nitratos, licuación de la gelatina, utilización de la glucosa O/F y no se desarrollaron a 41°C. Hidrolizaron la esculina y la arbutina útiles para determinar la producción de β–glucosidasa (Figura 3).
Producción de siringomicina. La zona de inhibición, medida desde la colonia bacteriana P001, fue en promedio de 11,5 mm, indicando que se produjo la toxina bacteriana siringomicina, evitando así el desarrollo del hongo alrededor de la colonia bacteriana, contrario al testigo, donde el hongo se desarrolló completamente en la caja Petri. La colonia bacteriana Pst probada, no inhibió el desarrollo del hongo, lo cual indica que este patovar no produce la toxina siringomicina (Figura 4).

Utilización de fuentes de carbono. La bacteria Pseudomonas syringae pv. syringae (P001) y la cepa de referencia Pseudomonas syringae pv. tomato (Pst) utilizaron como fuente de carbono: manitol, inositol, sorbitol, trigonelline, erythritol, ácido L láctico, ácido L tartárico, arabinosa, ribosa, xilosa, mannosa,y sucrosa. La bacteria no se desarrolló en presencia de adonitol, tartrato, cellobiosa, ramnosa y maltosa. En betaine, la bacteria presentó una reacción variable. En la Tabla 1, se resume los resultados de las pruebas realizadas.

Discusión
En los cultivos de duraznero [Prunus persica (L.) Batsch] se reportan diferentes microorganismos que provocan marchitamientos vasculares, cánceres y muerte descendente, características de la enfermedad que se presentó en los municipios de Villamaría y Manizales (Caldas). Entre los hongos citados se encuentran los géneros Leucostoma, Verticillium, Ceratocystis, Phomopsis y Botryosphaeria (Gubler, 1995). No obstante, en la investigación realizada, no se encontraron crecimientos fungosos ni en cámara húmeda ni en las siembras en PDA. Entre las enfermedades bacterianas, se han mencionado como causantes las bacterias Pseudomonas syringae pv. syringae Van Hall y P. s. pv. persicae (Prunier et al.) Young et al. (Hatting et al., 1989). En la observación microscópica, luego de realizada la tinción de Gram, las bacterias aisladas en este trabajo aparecieron de color rosa–rojo, indicando que la bacteria es Gram negativa, reacción característica, según Del Río & Sauceda (1997), de la mayoría de bacterias patógenas de plantas. De los aislamientos realizados fue obtenida una bacteria que formó colonias de color blanco–crema–brillante, circular, convexa y de margen entera. La bacteria resultó catalasa positiva según la reacción descrita por Shaad (1988), aeróbica; con un tipo de metabolismo estrictamente respiratorio y no fermentativo. Las bacterias P001 y Pst. presentaron una reacción negativa a la prueba arginina dihidrolasa, oxidasa, y reducción de nitratos (Schaad, 1980).
Por las características mencionadas y según la descripción de Goto (1992), la bacteria objeto del estudio pertenece al género Pseudomonas: Gram negativa, con forma de bastón recto o de varillas levemente curvas de 0,5-1,0 x 1,5-5,0 mm, móviles, con uno ó dos flagelos polares. Por ser una bacteria fluorescente en medio King's B, oxidasa negativa, arginina dihidrolasa negativa, no reduce nitratos, no se desarrolla a 41°C y no utiliza como fuente de carbono celobiosa ni ramnosa para su desarrollo, pertenece a la especie syringae.
De los cuatro patovares de Pseudomonas syringae que atacan a los frutales caducifolios, en duraznero solo se han reportado los patovares syringae y persicae (Hatting et al., 1989). Teniendo en cuenta el esquema de Shaad (1988), el aislamiento P001 se ubica en el patovar syringae por ser levano y β–glucosidasa positiva, la cual utilizó para su desarrollo como fuente de carbono: manitol, inositol, sorbitol, erythritol, trigonelline y no se desarrolló en presencia de adonitol ni tartrato.
El aislamiento de la bacteria P001 presentó las siguientes características LOPAT propuestas por Lelliot et al. (1966): produce colonias tipo levano, es negativa para oxidasa, actividad pectolítica (ablandamiento de la papa) y arginina dihidrolasa, y elicita hipersensibilidad en tabaco, como lo señala Young (1995) para el patovar persicae. Pero se diferencia de éste porque Pseudomonas syringa pv. persicae no produce β–glucosidasa ni la toxina siringomicina, además no utiliza para su desarrollo inositol, erythritol ni trigonelline.
Pseudomonas syringae pv. syringae produce la toxina siringomicina, la cual inhibe el desarrollo de los hongos Geotrichum candidum y Rodothorula pilimanae (Lacovellis et al. 1992). El patovar persicae también produce toxinas llamadas persicomicinas las cuales presentan antibiosis a Bacillus thuringiensis (Barzic & Guittet, 1996). El aislamiento de la bacteria P001 produjo la toxina siringomicina ya que inhibió el desarrollo del hongo Geotrichum candidum. La bacteria Pseudomonas syringae pv. tomato (Pst) no inhibió el desarrollo del hongo, lo que indica que este patovar no produce la toxina siringomicina como lo indican Lacovellis et al. (1992).
La sintomatología de la enfermedad desarrollada por las plantas inoculadas consistió en secamiento de ramas, amarillamiento y flacidez de las hojas con su posterior caída, necrosamiento de ramas terminales y cánceres en los puntos de inoculación y exudados gomosos de color ámbar. Las pruebas de inoculación hechas a través de las ramas corroboran las observaciones de Hatting & Roos (1995) quienes indican que la bacteria P. syringae pv. syringae penetra por heridas hechas durante la poda, remoción de chupones y caída de hojas. Estos investigadores afirman que la bacteria P. syringae pv. syringae también puede colonizar la superficie foliar epifíticamente y luego traslocarse sistémicamente a través de la planta. No obstante, en las plantas inoculadas a través de las hojas solamente se presentó una quemazón típica de daño mecánico, sin repercusión vascular como ocurre por la acción de un microorganismo. Es posible que la bacteria permanezca en las hojas en forma epífita para luego entrar por heridas en tallos y ramas y traslocarse vía xilema como lo indica Agrios (2005).
Además, las observaciones de campo reportadas por los cultivadores indican que en épocas secas la enfermedad tiende a estabilizarse, lo cual coincide con lo reportado por Hatting et al. (1989), en el sentido que los períodos de lluvia, las temperaturas frías y la alta humedad incrementan la severidad de la enfermedad y favorecen la dispersión e infección de P. syringae pv. syringae.
El procedimiento metodológico desarrollado en esta investigación permitió obtener la información suficiente para el diagnóstico correcto del agente causante de la Muerte descendente del duraznero, reportada en la región objeto del estudio. Aunque es el primer trabajo de identificación en Colombia, la bacteria seguramente está presente en las otras áreas de desarrollo del duraznero como Boyacá, Cauca y Santander, pero no causa los daños reportados debido a factores ambientales menos favorables a la bacteria.
Conclusiones
La sintomatología de la enfermedad reportada en los cultivos de duraznero de las variedades Newball, Sapote, Florida y Amarillo de los municipios de Villamaría y Manizales (Caldas), ha sido descrita como flacidez de las hojas, con posterior defoliación, secamiento de ramas y muerte de la planta. Las ramas presentan lesiones con aspecto de cáncer con exudados gomosos; al hacerles cortes transversales, se observa una coloración parda oscura, que va en forma descendente a través de ramas y tallos. En las pruebas de inoculación hechas a través de las ramas, la bacteria rápida y consistentemente expresó la sintomatología observada en campo: marchitamiento, clorosis en hojas seguida por necrosamiento y posterior caída de las hojas, cánceres en los tallos con exudados gomosos y daños vasculares.
Las pruebas patológicas, fisiológicas y morfológicas realizadas indicaron de manera consistente que la causa de la enfermedad conocida como Muerte descendente o Cáncer bacteriano en duraznero (Prunus persica) en los municipios de Villamaría y Manizales es la bacteria Pseudomonas siringae pv. syringae.
La bacteria se encontró asociada con la enfermedad y fue aislada de ramas y tallos donde se presentaba el avance de la enfermedad. La bacteria se purificó y se inoculó en plantas sanas, las cuales expresaron los mismos síntomas observados en el campo. Finalmente, la bacteria fue reaislada de las plantas inoculadas y a las pruebas realizadas se encontraron las mismas características de la bacteria inoculada, cumpliendo así con los postulados de Koch.
Bibliografía
Agrios, N. G. 2005. Plant pathology. 5th edition USA . Elsevier Academic Press. 922 p. [ Links ]
AGRONET. 2009. Análisis estadísticos. Web site: http://www.agronet.gov.co: 13 may. 2011. [ Links ]
Barzic, M. R. & Guittet, E. 1996. Structure and activity of persicomycins, toxins produced by a Pseudomonas syringae pv. persicae/Prunus persica isolate. European Journal of Biochemistry 239:702-709. [ Links ]
Byther, R. S. 1981. Bacterial canker of Prunus. Bulletin. Washington N° 1013. pp. 1-2. [ Links ]
Campos, T. E. 1993. Historia de los frutales caducifolios en Colombia. En: Sarmiento, A. S. y Naranjo, C. O. Editores. Frutales Caducifolios. Bogotá. Presencia. 7p. [ Links ]
Del Río, L. & Sauceda, N. 1997. III. Bacterias fitopatógenas. En: Manual para el diagnóstico de hongos, bacterias, virus y nematodos fitopatógenos. Castaño-Zapata, J. y Del Río, L. Editores. Centro Editorial Universidad de Caldas-Zamorano Academic Press 210 p. [ Links ]
Goto, M. 1992. Fundamentals of bacterial plant pathology. San Diego. Academic Press 342 p. [ Links ]
Gross, D. C. & DeVay, J. E. 1977. Production and purification of syringomycin, a phytotoxin produced by Pseudomonas syringae. Physiological Plant Pathology 11:13-28. [ Links ]
Gubler, W.D. 1995. Cankers, blights, and wood rots. In: Ogawa, J. M.; Zehr, E. Y.; Ritchie, D. F. and Uyemoto, J. K. (editors). In: Compendium of Stone Fruit Diseases St. Paul, APS Press. Pp. 41. [ Links ]
Hattingh, M. J.; Roos, M. I. & Mansvelt E. L. 1989. Infection and systemic invasion of deciduous fruit trees by Pseudomonas syringae in South Africa. Plant Disease 73(10):784-789. [ Links ]
_____. 1995. Diseases caused by bacteria: Bacterial canker. In: Compendium of Stone Fruit Diseases St Paul. APS Press. pp. 48-50. [ Links ]
Lacobellis. N. S.; Lavermicocca, P.; Grgurina, I.; Simmaco, M. & Ballio, A. 1992. A. Phytotoxic properties of Pseudomonas syringae pv. syringae toxins. Physiological and Molecular Plant Pathology 40:107-116. [ Links ]
Lelliot, R. A., Billing, E. & Hayward, A. C. 1966. A determinative scheme for the fluorescent plant pathogenic pseudomonads. Journal Applied Bacteriology 29:470-489. [ Links ]
Molina, G.D., & Parra, G. T. 2007. Producción de durazno en América Latina y Colombia. Semillero de Investigación de Economía. Internet: (http://www.geomundos.com/cultura/corpochitaga/ produccion-de-durazno-en-america-latina-y-colombia_ doc_17071.html). Acceso: 02 May. 2009. [ Links ]
Noval, C. 1991. Bacterias. Manual de laboratorio. Diagnóstico de hongos, bacterias y nemátodos fitopatógenos. Madrid : Ministerio de Agricultura, Pesca y Alimentación. Pp.113-275. [ Links ]
Pachón, G.O. & Bridg, H. 1993. Micropropagación in vitro del durazno blanco común (Prunus persica L.). Agricultura Tropical (Colombia) 30(1):101. [ Links ]
Shaad, N. W. 1988. Laboratory guide for identification of plant pathogenic bacteria. 2 ed. St. Paul. Minnesota : American Phytopathological Society pp.60-68. [ Links ]
_____. 1980. Laboratory guide for identification of plant pathogenic bacteria. Departament of Plant Pathology. University of Georgia. Pp. 60-77 [ Links ]
Tello, J., Vares, F. & Lacasa, A. 1991. Manual de laboratorio. Diagnóstico de hongos, bacterias y nematodes fitopatógenos. Madrid. Ministerio de Agricultura, Pesca y Alimentación. Pp. 79-82. [ Links ]
Young, J. M. 1995. Bacterial decline. In: Ogawa, J. M.; Zehr, E. Y.; Ritchie, D. F. and Uyemoto, J. K. (editors). In: Compendium of Stone Fruit Diseases. St Paul APS. Pp. 50. [ Links ]
Recibido: febrero 18 de 2011. Aceptado para su publicación: febrero 28 de 2011.













